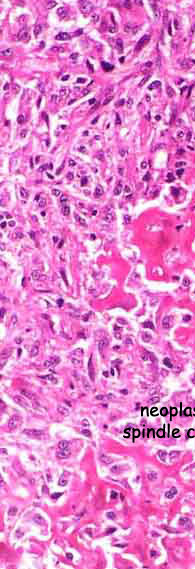
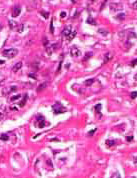
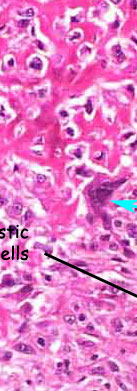

Introduction
Mass:
 |
||
|
|
 |
|
||
| |
|||||||||||
Introduction |
Mass:
(x200) |
||||||||||
Lymphatic Invasion |
|||||||||||
Transplantation |
|||||||||||
Haematogenous Spread |
|||||||||||
Review Questions |
|||||||||||
Back to Prac Classes |
|||||||||||
| |
|||||||||||